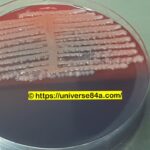
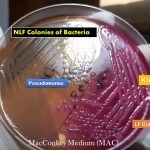

Tag: Medlaboslutions9
E. cloacae: Introduction, Morphology, Pathogenicity, Lab Diagnosis, Treatment, Prevention, and Keynotes
Introduction Enterobacter cloacae is a species of Gram-negative bacteria that falls...
Introduction Enterobacter cloacae is a species of Gram-negative bacteria that falls...
Catalase Test: Introduction, Principle, Procedure , Result Interpretation and Precautions
 Introduction of Catalase Test Catalase test is used to differentiate...
Introduction of Catalase Test Catalase test is used to differentiate...
MAC: Introduction, Principle, Composition, Preparation, Procedure, Colony Morphology and Uses
Introduction of MAC MAC stands for MacConkey medium or agar...
Introduction of MAC MAC stands for MacConkey medium or agar...
